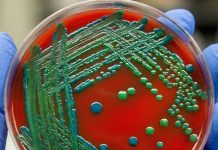
Metisiline Dirençli Staphylococcus Aureus (MRSA) Enfeksiyonu

Bu İçerik Sadece Aboneler İçindir
Suda boğulma, suya battıktan sonra nefessiz kalma sonucu gelişen ölüm olarak tanımlanır. Dünya Sağlık Örgütü’nün (WHO) verilerine göre, dünya çapında önlenebilir yaralanmalar arasında ölüme yol açan üçüncü en yaygın nedendir. Hem can kaybı hem de sakatlıklar ile sonuçlanabilmesi, iş gücü kaybına yol açabilmesi ve önlenebilir risk faktörleri içermesi nedeniyle suda boğulma, hem dünya çapında hem de ülkemizde önemli bir halk sağlığı sorunudur.
Suda Boğulmanın Dinamikleri ve Özellikleri
- Boğulma Hızı ve Sessizliği: Boğulma genellikle hızlı bir şekilde gerçekleşir. Çoğu durumda, boğulma sessizdir; suda çırpınan bireyler nadiren görülür. İnsanlar, boğulma sırasında suyun içinde çılgınca hareket etmezler.
- Klasik Senaryo: Suda yüzen ve yüzeyin altında hızla kaybolan bir birey, boğulma sürecinin klasik senaryosunu oluşturur. Bu durum, boğulmanın genellikle sessiz bir şekilde, çoğunlukla gözle görünmeden meydana geldiğini gösterir.
Suda boğulmanın genellikle aniden gelişmesi ve sessiz olması, çoğu zaman fark edilmeden gerçekleşmesine neden olur. Bu sebeple, suda boğulmaya yönelik hızlı müdahale çok önemlidir.

ETİYOLOJİ
Kazara veya kasıtlı olarak suya ya da vücudun dokularını ve organlarını oksijenlendirme yeteneğini engelleyen diğer sıvı maddelere maruz kalma. Bebeklerde neden genellikle kazayla olur ve küvette ya da hatta yıkanma kovasında gerçekleşebilir. Bebek ölümlerinin çoğu, gözetimin 5 dakika gibi kısa bir süre aksaması sonucu meydana gelir. Daha büyük çocuklar genellikle yüzme havuzunda boğulur. Çoğu zaman havuzun kapısı veya çiti açıktır ve çocuk doğrudan atlar. Yetişkinler ise göl, nehir ve denizde boğulma eğilimindedir. Yetişkinlerdeki birçok boğulma vakasında sığ suya dalarken kayaya çarpma gibi ilişkili bir yaralanma da olabilir.
EPİDEMİYOLOJİ
Boğulma olgularının yarısından fazlası 25 yaş altındaki bireylerde görülürken, özellikle 5 yaş altı çocuklar ve genç erkek erişkinler (15-29 yaş) arasında ciddi bir halk sağlığı sorunu teşkil etmektedir.
- Dünya Genelinde Durum: Suda boğulma, dünyanın her bölgesinde, özellikle 1-24 yaş arasındaki bireylerde en sık görülen önlenebilir ölüm nedenlerinden biri olarak kabul edilmektedir.
Türkiye’de Boğulma Oranı
Türkiye’de, her yıl ortalama bin kişi suda boğularak hayatını kaybetmektedir. Türkiye’nin üç tarafının denizlerle çevrili olması, zengin su kaynaklarına sahip olması ve tarımda açık su kanallarının kullanılması gibi faktörler, boğulma oranlarının yüksek olmasına neden olmaktadır.
- Mevsimsel Faktörler: Suda boğulmaların %50.45’inin yaz mevsiminde meydana gelmiş olması, özellikle sıcak aylarda insanların serinlemek amacıyla yüzmeyi tercih etmeleri ile ilişkilidir. Bu olaylar en sık ağustos ayında görülmektedir.
- Kış Ayları: Kış aylarında ise boğulma vakaları, genellikle kapalı havuzlar, termal tesisler ve balık tutma amacıyla kullanılan baraj göllerinde yaşanmaktadır.
Önemli Risk Grupları ve Önlenebilirlik
- 5 Yaş Altı Çocuklar: Bu yaş grubundaki çocuklar, özellikle yüzme bilmedikleri ya da denetim altında olmadıkları durumlarda yüksek risk altındadır.
- Genç Erkekler (15-29 Yaş): Genç erkekler arasında, yüzme, dalış gibi aktiviteler sırasında boğulmalar daha sık görülmektedir. Bu grup, riskli aktivitelerde bulunurken genellikle öngörülemeyen tehlikelerle karşılaşabilmektedir.
Suda boğulma, toplumda ciddi sağlık sorunlarına yol açan bir olgu olmasına rağmen, çoğu zaman önlenebilir bir durumdur. Eğitim, erken müdahale ve bilinçlendirme ile bu oranların azaltılması mümkündür.
PATOFİZYOLOJİ
Suda Boğulma Tanımı
Suda boğulma, sıvıların solunum yollarına girmesi sonucu, akciğerlerdeki alveollere kadar ilerleyerek kişinin ölümüne yol açan bir mekanik asfiksi durumudur. Boğulma, genellikle panik hali, nefes tutma, hava açlığı ve suyun yüzeyinde kalma mücadelesi ile başlar. Sonrasında, refleks olarak inspiratuar çabalar meydana gelir ve su, solunum yolları ile temas ettiğinde, ya aspirasyon ya da laringospazm yoluyla hipoksemiye yol açar.
Tuzlu Su ve Tatlı Su Boğulması
Önceki literatür, tuzlu su ile tatlı su arasında belirgin bir fark olduğuna işaret etmiştir. Tuzlu suyun hipertonik özellikleri, plazmanın pulmoner interstisyum ve alveollere çekilmesine neden olarak masif pulmoner ödem ve hipertonik seruma yol açmaktadır. Tatlı su boğulmasında ise, aspire edilen hipotonik sıvı, hızla akciğerlerden intravasküler kompartmana geçerek aşırı hacim yüklenmesine ve serum elektrolitlerinde seyreltici etkilere yol açar. Ancak, araştırmalar bu farkın, hastaneye canlı getirilen kişiler ile ölümle sonuçlanan vakalar arasında daha belirgin olduğunu göstermiştir. Bu yüzden, günümüzde bu ayrım genellikle önemli görülmemektedir.
Boğulma Türleri
Boğulma, sıvının solunum yollarına geçip geçmemesine göre ıslak (tipik) veya kuru (atipik) olarak sınıflandırılabilir. Ancak, yapılan postmortem incelemelerde, akciğerlerde çok az miktarda sıvı bulunduğu ve akciğerlerin suyla dolmadığı görülmüştür. Bu nedenle, bu sınıflandırmalar artık kabul edilen terimler değildir.
Boğulmanın Patofizyolojisi
Boğulmadaki temel patofizyolojik olaylar hipoksi ve asidozdur. Suya batma sonucu suyun yutulması, kazazedelerde apne ve laringospazm gelişmesine yol açar, buna bağlı olarak hipoksi oluşur. Hipoksi sonrasında gelişen asidoz, kardiyovasküler kollaps ve santral sinir sistemi iskemisine neden olabilir.
Asfiksi durumu solunum yollarında gevşemeye yol açar ve akciğerlere sıvı geçişi olur. 22 mL/kg’dan fazla sıvı aspirasyonu, alveolo-kapiller alışverişi bozar, PaO2’yi düşürür ve dokularda hipoksi gelişimine neden olarak asidoz ortaya çıkar. Aspirasyon sonrası akciğerlerde ARDS (Akut Solunum Sıkıntısı Sendromu) gibi bir klinik tablo gelişebilir.
- Alveolar-kapiller membranın geçirgenliğinin artması, akciğer kompliansının azalması ve ventilasyon/perfüzyon uyumsuzluğu da bu tabloyu ağırlaştırır.
- Ayrıca aspirasyon sonucu gelişen ikincil enfeksiyonlar ve sürfaktan tükenmesi akciğer hasarını artırabilir.
Sıvı Miktarı ve Elektrolit Düzeyleri
Aşırı aspirasyon yapan hastalarda sıvı miktarı arttıkça elektrolit değişiklikleri de görülür. 3-4 mL/kg ve üzerindeki sıvı aspirasyonu, alveolo-kapiller alışverişi bozarak PaO2’yi düşürür ve hipoksiye neden olur. Bu da asidozu tetikler.
Hipotermi ve Boğulma
Boğulma vakalarında hipotermi sıkça görülen bir durumdur. İnsan vücudu normal fonksiyonlarını sürdürebilmek için 37°C sıcaklığa ihtiyaç duyar. Vücut sıcaklığı 35°C’nin altına düştüğünde kaslarda koordinasyon bozukluğu ve güçsüzlük gelişir, 30°C’nin altına inildiğinde bilinç kaybı ve myokard irritabilitesi gözlemlenir. 25°C’nin altındaki vücut ısısı, ventriküler fibrilasyon ve kardiyak arrest ile sonuçlanabilirken, 18°C’ye düşen vücut ısısı asistole yol açar.
Çocuklarda hızlı gelişen hipotermi, santral sinir sistemi üzerinde koruyucu bir etki gösterebilir. Ciddi hipotermide (vücut ısısı 30°C’nin altında), resüsitasyona vücut ısısı 30°C’yi geçene kadar devam edilmelidir.
Sıvı Elektrolit Düzeyleri ve Enfeksiyon Riski
- Tatlı su boğulmalarında sıklıkla hiponatremi görülürken, tuzlu su boğulmalarında hipernatremi ve hiperkloremi izlenir.
- Nadiren hiperkalsemi ve hipermagnezemi de görülmektedir. Bu durumlar, hastanın sıvılarla kontamine olup olmadığına göre değişir.
Kontamine sıvılar, pulmoner enfeksiyon riski taşıdığından, profilaktik antibiyotikler başlanmalıdır.
Sonuç ve Klinik Yönetim
Suda boğulma, hızlı bir şekilde gelişebilen ve ciddi sonuçlar doğurabilen bir acil durumdur. Erken müdahale, solunum yolu yönetimi ve sıvı elektrolit dengelemesi, hastaların hayatta kalma şansını artırabilir. Ayrıca, hipotermi ve sıvı elektrolit dengesizliklerinin yönetimi, boğulma sonrası iyileşme sürecinde kritik öneme sahiptir.
RİSK FAKTÖRLERİ
Dalışla İlgili Risk Faktörleri:
- Yetersiz yetişkin gözetimi
- Yüzme bilmeme veya yüzme yeteneğinin fazla tahmin edilmesi
- Risk alma davranışı
- Alkol ve yasadışı uyuşturucu kullanımı
- Kafa travması
- Nöbet, inme
- Kardiyak aritmi, miyokard enfarktüsü
- Hipoglisemi
- Hipotermi
- İntihar
- Panik atak
- Depresyon
- Dalma
- Doğal afetler

Dalış Öncesi Hiperventilasyonun Tehlikeleri: Dalış öncesi hiperventilasyon yapan dalıcılar özellikle risk altındadır. Hiperventilasyon, normalden daha hızlı ve derin nefes almayı içeren bir tekniktir. Bu şekilde kandaki karbondioksit seviyesi düşürülür ve beynin nefes alma güdüsü büyük ölçüde kandaki karbondioksit miktarına bağlı olduğundan, hiperventilasyonla başlayan bir dalışta dalıcının nefes alma güdüsü baskılanarak %40’a kadar daha uzun süre nefes tutması sağlanabilir.
Dalış sırasında hiperventilasyon sayesinde kandaki karbondioksit seviyesi düşer, bu da dalıcıya büyük konfor sağlar ve nefes alma ihtiyacı hissetmez. Ancak dalıştan çıkarken, özellikle 5 metre civarında basınç azaldığında, oksijen dokular tarafından daha hızlı emilir. Bu durum, serebral hipoksiye (beyin oksijen eksikliği) yol açarak bayılma ve nöbetlere neden olabilir. Bayılmalar genellikle dalıcı yalnızsa ölümle sonuçlanabilir.
Bebeklerde ise neden genellikle ebeveynlerin ihmaline bağlı küvette veya hatta banyo kovasında meydana gelebilir. Daha büyük çocuklar yüzme havuzunda gerçekleşirken genellikle havuzun kapısı veya çiti açıktır ve çocuk sadece atlar. Yetişkinler ise daha çok göllerde, nehirlerde ve denizde boğulurlar ve suda boğulma olgularının % 53’ünde alkol kullanımı sorumlu tutulmuştur. Ayrıca epileptik hastalar tedavilerine ara vermemiş olsalar bile, normal popülasyona kıyasla, dört kat daha fazla risk altında olduklarından, suda devamlı gözlem altında tutulmalıdırlar.
FİZİK MUAYENE
Boğulmuş veya boğulmak üzere olan hastalar, asemptomatik olabileceği gibi, rigor mortis (ölüm sertliği) durumunda da olabilirler. Bu hastalar genellikle hipotermiktir.
Boğulma öyküsü olan bir hasta, genellikle uzun bir süre suda kaldıktan sonra nefes almakta güçlük çekmiş olabilir.
- Solunum: Çoğu hastada solunum hızlı olabilir. Cilt, kandaki oksijen eksikliği nedeniyle morarmış veya soluk görünebilir. Hasta, apne (nefes almayı durdurma) veya nefes darlığı şikayetleri ile başvurabilir.
- Bilinç durumu: Hastada bilinç düzeyinde değişiklikler, öksürük, yorgunluk veya başka nörolojik bulgular da görülebilir. Solunumları düzensiz, bazen iç çeker tarzda olabilir.
- Akciğer Muayenesi: Aşırı sıvı aspirasyonuna bağlı boğulmaların ardından, akciğer ödemi gelişebilir ve bu durum akciğer muayenesinde raller (yaralı sesler) ile kendini gösterir.
- Kardiyovasküler Bulgular: Boğulma sırasında kardiyovasküler instabilite görülebilir. Buna bağlı olarak taşikardi (hızlı kalp atışı), bradikardi (yavaş kalp atışı) ve ventriküler fibrilasyon (kalbin düzensiz atışı) gibi bulgular ortaya çıkabilir.
LABORATUVAR
Ölümcül olmayan boğulma vakalarında, hastaların elektrolit düzeyleri genellikle normaldir. Elektrolit anormallikleri, bu hastalarda nadiren görülür.
RADYOLOJİ
Tüm boğulma mağdurlarında göğüs röntgeni gerekli değildir. İlk göğüs röntgeni, hastanın klinik seyri veya sonucu ile genellikle çok az bir korelasyona sahiptir. Ancak, solunum sıkıntısı olan hastalarda akciğer filmi istenmelidir.
TEDAVİ
Boğulma olaylarında, acil çağrı sisteminin erken aktive edilmesi ve erken müdahale mortaliteyi önemli ölçüde etkilemektedir. Ayrıca, erken müdahale ve uygun resüsitasyon uygulamalarının erken başlatılması, nörolojik sekelin azaltılması açısından kritik bir rol oynar. Yetişkin boğulma olgularında, öncesinde alkol ve yabancı madde kullanımı mutlaka sorgulanmalıdır.
Boğulma kurbanlarının yönetimi üç aşamaya ayrılabilir:
- Hastane öncesi bakım ve akut müdahaleler
- Acil servis bakımı
- Yatan hasta bakımı
Boğulma kurbanlarının yönetimi için rehberlik edecek yüksek kaliteli kanıtlar sınırlıdır; bu kılavuzlar, gözlemsel çalışmalardan ve klinik deneyimlerden elde edilen bilgilerle oluşturulmuştur.
HASTANE ÖNCESİ YAKLAŞIM
Suda boğulmalarda sağ kalım zinciri beş halkadan oluşmaktadır:
- Suda gerekli önlemlerin alınması (can yeleği gibi)
- Sıkıntının önceden tanınması
- Kurbanı su üzerinde tutma (can simidi gibi)
- Sudan çıkarma
- Tıbbi müdahale
Ölümcül olmayan boğulmalarla ilişkili en büyük morbidite ve mortalite, doku hipoksisine, özellikle de serebral hipoksiye bağlıdır. Bu nedenle, resüsitasyon sürecindeki en büyük öncelik, hipoksiyi hızlı bir şekilde düzeltmektir. Resüsitasyon işleminin hızlı başlanması ve mutlaka kurtarıcı soluklar ile başlatılması gereklidir. Bu bağlamda, suda boğulma olgularında yapılması gereken en önemli işlem, mağdurun su içinden hızlı bir biçimde çıkarılmasını sağlamaktır. Eğer mağdur bilincini kaybetmediyse, can simidi, ip veya tahta gibi cisimlere tutunarak ortamdan uzaklaştırılmaya çalışılmalıdır.
Etrafta bulunan kişiler ve sağlık personeli suda kurtarma konusunda yeterli eğitime ve yüzme kabiliyetine sahip değilse, kesinlikle suya girilmemelidir. Eğer suya girilmesi gerekiyorsa, su araçları kullanılması önerilir. Eğitimsiz kişilerin suya girerek kazazedeyi kurtarmaya çalışmaları, ikincil boğulma olaylarının görülmesine yol açabilir. Eğer mağdur bilincini kaybettiyse, ventilasyon (soluk verme) kurtarıcı, sığ suya veya sabit bir yüzeye (tekne, kara vb.) ulaşır ulaşmaz başlanmalıdır. Eğer hasta karaya uzak mesafedeyse, su içerisinde resüsitasyon (SİR) uygulanması faydalı olabilir, ancak bu konuda yeterli bilgi mevcut değildir. Hastanın güvenli CPR yapılacak bir ortama taşınması öncelikli olmalıdır ve bunun için zaman kaybedilmemelidir.
Su içindeki resüsitasyon sadece ventilasyondan ibaret olmalıdır çünkü sabit bir yüzey olmadığı için etkili göğüs kompresyonu sağlanamaz. Yeterli eğitimi olan kurtarıcılar, su içi resüsitasyonu 5 kurtarıcı soluk ile başlatmalıdır. Su içinde kardiyak kompresyon uygulanmamalıdır, çünkü etkisiz olacaktır ve asıl sorun olan hipoksemi ve hipoksinin tedavi edilmesine yönelik yoğunlaşılmalıdır.
Karaya veya sabit bir yüzeye ulaşır ulaşmaz, hastanın solunumu ve dolaşımı tekrar değerlendirilmelidir. Hasta nefes almıyor veya nabzı alınamıyorsa ya da nabzın varlığından emin olunamıyorsa, vakit kaybetmeden resüsitasyona başlanmalı ve 30:2 ve standart TYD veya İYD algoritmalarına devam edilmelidir.
Resüsitasyonun başında, havayolu açıklığının sağlanması ve oksijenizasyon öncelikli olmalıdır. Kardiyak arrest hastasında, geleneksel ABC modeline uygun şekilde göğüs kompresyonuna ek olarak pozitif basınçlı ventilasyon sağlanmalıdır. Eğer ileri hava yolu sağlanmışsa, her 6-8 saniyede bir aralıklı nefes verilmeli ve göğüs kompresyonu sürekli olmalıdır. Eğitimi olmayan kurtarıcılar için, herhangi bir müdahalede bulunmamaktansa yalnızca göğüs kompresyonu yapmak tercih edilebilir.
Boğulma hastalarına resüsitasyon yapılırken, en kısa sürede mümkün olan en yüksek konsantrasyonda oksijen başlanmalıdır. Solunum sıkıntısı çeken veya arrest hastalarda, pasif ventilasyon yerine pozitif basınçlı ventilasyon tercih edilmelidir ve ağızdan ağıza solunum yerine balon-valf maskesi kullanılmalıdır. İleri yaşam desteğinde ise, standart kılavuza uygun algoritmalar kullanılmalı ve otomatik harici defibrilatör (OED) uygulanmalıdır.
Boğulmuş hastalarda genellikle asistoli görülmektedir, nadiren ventriküler taşikardi veya ventriküler fibrilasyon görülebilir. Bu yüzden OED bulma çabası, hastanın havayolu açıklığını ve oksijenizasyonunu sağlamanın önüne geçmemelidir. OED ıslak ortamlarda kullanılabilir, bu konuda bir kontraendikasyon yoktur. Ancak 112 personeli tarafından hastanın monitörizasyonu sağlanıp defibrilasyon işlemi yapılacaksa, defibrilasyon öncesi hastanın göğsü mutlaka kurulanmalıdır.
Rutin servikal omurga immobilizasyonu önerilmektedir. Eğer suda boğulmanın sebebi travma (örneğin, sığ suya dalış) veya su sporları gibi yüksek enerjili aktivitelerse, servikal yaralanma ihtimali göz önünde bulundurularak servikal immobilizasyon sağlanmalıdır.
Spontan solunum yapan hastalar için yüksek akışlı oksijen (%100) başlanmalıdır. Acil entübasyon gerektirmeyen semptomatik hastalarda, SpO2’yi %94’ün üzerinde tutmak hedeflenmelidir. Solunum sıkıntısı çeken veya nörolojik bozulma belirtileri veya hava yolunu koruyamayan, oksijen satürasyonu %90’ın altında kalan olgular entübe edilmelidir. Vücut sıcaklığı <33ºC olan hipotermik hastalar için yeniden ısıtma girişimleri mümkün olduğunca pasif veya aktif yollarla başlatılmalıdır.
UYARI – ÖNLEMLER
- Heimlich manevrası veya akciğerlerden suyu uzaklaştırmaya yönelik diğer postural drenaj tekniklerinin, boğulma olaylarında kanıtlanmış bir değeri olmadığı için uygulanmaması gerektiği ve kurtarıcı solunumun geciktirilmemesi gerektiği vurgulanmalıdır. Ayrıca, hipotermik hastalarda göğüs kompresyonlarına başlamadan önce dikkatli bir nabız değerlendirmesi yapılmalı, çünkü hipoglisemi ve hipotermi hastaların kardiyovasküler yanıtlarını değiştirebilir.
- Boğulma sonrası hastalar, hayatı tehdit eden aritmilerle başvurabileceği için bu aritmilerin protokollerine uygun şekilde tedavi edilmesi önemlidir. Özellikle kalp durması durumu varsa, acil kardiyak resüsitasyon (CPR) derhal başlatılmalıdır.
- Ayrıca, CPAP (sürekli pozitif hava yolu basıncı) veya BPAP (iki düzeyli pozitif hava yolu basıncı) kullanımı, boğulma sonrası oksijenasyonun iyileştirilmesi ve ventilasyon-perfüzyon uyumsuzluğunun azaltılmasına yardımcı olabilir. Bu cihazlar, akciğerlerdeki havalanmayı destekleyerek hastanın oksijen seviyelerini iyileştirmeyi hedefler. Ancak, pozitif hava yolu basıncının intratorasik basıncı artırması nedeniyle, hipotansiyon riski taşıyan hastaların dikkatli izlenmesi gerekmektedir.
- Son olarak, boğulma sonrası hastalarda glikoz ölçümü yapılması, hipogliseminin sıklıkla göz ardı edilen bir durum olabileceği ve bunun tedavi edilmesinin hastanın durumunun iyileşmesine katkı sağlayabileceği unutulmamalıdır.
ACİL SERVİS
Hastane öncesi resüsitatif müdahalelere acil serviste devam edilmeli ve hava yolu güvence altına alınmalıdır. Ölümcül olmayan boğulma kurbanlarının çoğu, hastalığın ciddiyeti veya klinik bozulma endişesi nedeniyle hastaneye kaldırılmaktadır.
Hastalar tam monitörize edilmeli, vital bulgular izlenmeli, oksijen satürasyonu, end tidal karbondioksit oranı ve kardiyak takip yapılmalıdır.
Hafif solunum sıkıntısı çeken veya hava yollarını koruyan entübasyon ihtiyacı olmayan hastalar
Hafif solunum sıkıntısı çeken veya hava yollarını koruyan, entübasyon gerektirmeyen hastalarda, semptomatik hastalarda SpO2’nin %94’ün üzerinde tutulması için ek oksijen sağlanmalıdır. Oksijen satürasyonu 94-98 aralığında olacak şekilde titrasyon yapılmalıdır. Eğer satürasyon güvenli bir şekilde ölçülemiyorsa, hızlıca kan gazı değerlendirmesi yapılmalıdır. Oksijen seviyesi %94’ün üzerinde, 94-98 aralığında tutulmalı, PaO2 basıncı ise 75-100 mmHg arasında hedeflenmelidir.
Resüsitasyon sırasında regürjitasyon ve aspirasyon riski göz önünde bulundurulmalı; gelişmesi durumunda mide içeriği hızla solunum yollarından uzaklaştırılmalıdır. Regürjitasyon olasılığına karşı erken entübasyon düşünülmelidir. Ağızdan gelen köpük temizlenmesi genellikle faydasızdır. Eğer gastrik içerik ve köpük ventilasyonu engelliyorsa, hasta yan yatırılmalı ve mümkünse aspiratör ile temizlenmelidir.
Hızlıca damar yolu açılmalı ve sıvı desteği sağlanmalıdır. Hastalarda glukoz ölçümü yapılmalı, ayrıca yetişkin hastalarda alkol veya madde intoksikasyonu açısından değerlendirme yapılmalıdır. EKG çekilmeli ve değerlendirilmelidir.
Solunum sıkıntısı olan hastalarda aşağıdaki tetkikler istenmelidir:
- Kan gazı
- Akciğer grafisi
- Hemogram
- Geniş biyokimya paneli
Ayrıca, sürekli pozitif hava yolu basıncı (CPAP) veya iki düzeyli pozitif hava yolu basıncı (BiPAP) ile noninvaziv pozitif basınçlı ventilasyon, oksijenasyonu iyileştirebilir ve ventilasyon-perfüzyon uyumsuzluğunu azaltabilir. Pozitif hava yolu basıncı uygulanan hastalarda, intratorasik basıncın arttığı ve olası hipotansiyon nedeniyle dikkatli izlenmesi gerektiği unutulmamalıdır.
Hipotermi durumunda, vücut sıcaklığı <35°C ise hastanın ısıtılması sağlanmalıdır. Hipotermik hastalarda ıslak giysiler çıkarılmalı ve ısıtma işlemi başlatılmalıdır. Hipoterminin nöroprotektif etkileri göz önüne alındığında, hipotermik hastalarda resüsitasyon süresi uzatılmalı ve hastanın vücut sıcaklığı 32-35°C’ye ulaşana kadar sürdürülmelidir.
Rutin servikal omurga immobilizasyonu önerilmektedir. Ancak travma öyküsü (örneğin, sığ suya dalma) veya yaralanma belirtileri varsa, servikal kollarda önlem alınmalı ve gerekli tetkikler yapılmalıdır.
Solunum sıkıntısı çeken veya hava yollarını koruyamayan;
Solunum sıkıntısı çeken veya hava yollarını koruyamayan, nörolojik bozulma belirtileri gösteren hastalar, yüksek akışlı oksijen iletim sistemi veya invaziv olmayan ventilasyon kullanılmasına rağmen PaO2’nin 60 mmHg’nin altında veya oksijen satürasyonu (SpO2) %90’ın altında ise entübe edilmelidir.
İntensive Care Unit (İYD) tedavisinde erken entübasyon önerilmektedir. Nabız kontrolü her zaman başarılı olmayabileceği için ETCO2 takibi önerilen uygulamalar arasındadır.
Entübe olan hastalara gastrik dekompresyon uygulanmalıdır. Ölümcül olmayan boğulma hastalarında, pasif sıvı geçişinden kaynaklanan mide şişkinliğini gidermek için orogastrik tüp yerleştirilmelidir.
Serebral oksijen tüketimini ve kan akışını artıran nöbet aktiviteleri agresif bir şekilde kontrol edilmelidir. Sedatif olmayan antikonvülsanlar (örneğin, fenitoin), bilinci baskılamadığı için tercih edilir ve nörolojik değerlendirmeyi zorlaştırmaz. Nöromüsküler blokajdan mümkünse kaçınılmalıdır, çünkü bu ajanlar nörolojik belirtileri maskeleyebilir.
Hem hipoglisemi hem de hiperglisemi beyne zarar verebilir; bu nedenle, öglisemi titizlikle korunmalıdır. Hipervolemiyi önlemek için diüretikler kullanılabilir, ancak hacim azalmasının kalp debisini ve serebral perfüzyonu olumsuz etkileyebileceği için dikkatli olunmalıdır.
Profilaktik antibiyotiklerin rutin kullanımı şu anda önerilmemektedir. Ancak, hastada enfeksiyon belirtileri veya semptomları gelişirse veya kurbanın aşırı derecede kontamine suya batmış olması durumunda antibiyotikler kullanılabilir. Ölümcül olmayan boğulmayı takiben pnömoni gelişirse, Aeromonas, Pseudomonas ve Proteus gibi su kaynaklı patojenlerle enfeksiyon düşünülmelidir.
Glukokortikoidlerin rutin kullanımı, ölümcül olmayan boğulma kurbanlarında desteklenen bir tedavi değildir. Ayrıca, ciddi şekilde stabil olmayan hastalarda ekstrakorporeal membran oksijenasyonu (ECMO) düşünülebilir, ancak bu tedavi için yüksek kaliteli kanıtlar eksiktir.
Terapötik hipotermi, ölümcül olmayan boğulmayı takiben resüsitasyon sonrası dönemde tartışmalı bir tedavi seçeneği olarak kalmaktadır. Terapötik (indüklenmiş) hipoterminin kullanımıyla ilgili yüksek kaliteli kanıt bulunmamaktadır. Birçok vaka serisi, terapötik hipotermi uygulandıktan sonra belirgin bir iyileşme olmadığını bildirmiştir. Ayrıca, nöbet eşiğini düşürdüğü için hipertermiden kaçınılmalıdır.
Yakın serebral herniyon tehlikesi olan hastalar için, hiperventilasyon akut bir önlem olarak intrakraniyal kan hacmini azaltarak intrakraniyal basıncı düşürebilir. Ancak, uzun süreli hiperventilasyondan kaçınılmalıdır çünkü bu durum vazokonstriksiyona, serebral kan akışının azalmasına ve serebral iskeminin kötüleşmesine yol açabilir.
Bilinçsiz ölümcül olmayan boğulma kurbanlarında barbitüratlar ve kontrollü hipotermi kullanımı, 1979’da çocuklarda mortalite ve nörolojik morbiditeyi azalttığı bildirilmişti. Ancak sonraki yıllarda yapılan çalışmalarda bu tedavilerin faydalı olmadığı gösterilmiştir. Örneğin, komada olan boğulmuş 31 çocuk üzerinde yapılan bir çalışmada, hafif hipotermi ile tedavi edilenlerle hafif hipotermi artı pentobarbital ile tedavi edilenler arasında sonuç farkı gözlemlenmemiştir.
Tekrarlanan göğüs radyografileri, pulmoner tutulumun ciddiyetini yansıtmayabilir ve yalnızca artan solunum sıkıntısı, azalan nabız oksimetresi veya hiperkarbi belirti ve semptomları durumunda yapılmalıdır. Bronkospazm, ölümcül olmayan boğulma kurbanlarında sık görülür ve yönetimi akut astım tedavisi ile benzer şekilde yapılır. Çoğu vaka, inhale beta-adrenerjik agonistlerle hızla düzelir.
Sürfaktan tedavisine dair vaka raporları olsa da, ölümcül olmayan boğulma mağdurlarında bu tedavi ile ilgili yüksek kaliteli kanıt bulunmamaktadır ve sürfaktan tedavisinin pulmoner fonksiyonu iyileştirdiği yönünde herhangi bir güvenilir sonuç bulunmamaktadır.
PROGNOZ
Su altında kalma yaralanmalarının ardından hayatta kalma olasılığına dair yapılan çalışmalar, genellikle büyük vaka kontrol çalışmaları ve vaka serileriyle sınırlıdır. Ancak, kötü prognoz ile ilişkilendirilen bazı önemli faktörler şunlardır:
- Daldırma süresi >5 dakika: Bu, en kritik faktörlerden biridir. Uzun süre su altında kalma, beyin hasarı ve diğer organlarda kalıcı zarara yol açabilir.
- Etkili temel yaşam desteğine kadar geçen süre >10 dakika: Temel yaşam desteğinin erken başlaması, hayatta kalma şansını önemli ölçüde artırır. 10 dakikadan fazla süreyle etkili yaşam desteği verilmemesi, kötü prognozla ilişkilidir.
- Resüsitasyon süresi >25 dakika: Resüsitasyon süresi uzadıkça, hayatta kalma oranları düşer. 25 dakikayı aşan sürelerde beyin ve organlarda irreversibl hasar meydana gelebilir.
- Yaş >14 yıl: Çocuklar, su altında kalma yaralanmalarından daha iyi iyileşme şansı sunan daha dayanıklı sistemlere sahip olabilir. Bu nedenle, 14 yaş ve üzeri bireylerde prognoz daha kötüdür.
- Glasgow koma ölçeği <5: Koma hali, beyin fonksiyonlarının ciddi şekilde bozulduğunu ve hayatta kalma şansının azaldığını gösterir.
- Acil serviste kalıcı apne ve kardiyopulmoner resüsitasyon gereksinimi: Kalıcı apne (nefes almama durumu) ve kardiyopulmoner resüsitasyon gereksinimi, hastanın ciddi şekilde hayatta kalma şansının azaldığını gösterir.
- Arteriyel kan pH <7,1: Şiddetli asidoz (kan pH’ının 7,1’in altında olması), vücutta metabolik bozuklukların ileri düzeye ulaştığını ve resüsitasyonun zorlaştığını gösterir.
Bu faktörler, su altında kalma sonrasında hayatta kalma ve iyileşme şansını tahmin etmeye yardımcı olabilir. Bu durumlar, tedavi sürecinin yoğunluğunu ve süresini belirleyen önemli kriterlerdir.
KORUMA
Boğulma, çoğu durumda önlenebilir bir durumdur. Bu konuda alınacak basit önlemler, boğulma vakalarının önemli ölçüde azaltılmasına yardımcı olabilir. Öne çıkan bazı önleme stratejileri şunlardır:
- Yüzme havuzlarının güvenli çitlerle çevrilmesi: Yüzme havuzları, özellikle dört yaşın altındaki çocukları korumak amacıyla güvenli (dört taraflı) çitler ve kapılarla çevrilebilir. Bu önlem, çocukların havuza girmesini engelleyerek boğulma riskini yaklaşık %80 oranında azaltabilir.
- Yeterli yetişkin gözetimi: Çocukların yüzme havuzlarında veya su kenarında bulunurken yeterince gözetim altında olmaları gereklidir. Yetişkinlerin sürekli olarak çocukları izlemesi, boğulma vakalarını önlemede önemli bir faktördür.
- Bir partnerle birlikte yüzme: Yalnız başına yüzme yapmak, özellikle suya girmeden önce hazırlıklı olmayan kişiler için risklidir. Yüzme sırasında bir partnerle olmak, acil bir durumda hızlı müdahale imkanı sağlar.
- Kişisel yüzdürme cihazlarının uygun kullanımı: Özellikle yüzme bilmeyen veya suya karşı dirençli kişiler için uygun kişisel yüzdürme cihazları (can yeleği gibi) kullanımı, boğulma riskini önemli ölçüde azaltabilir.
- Alkol ve yasadışı uyuşturuculardan kaçınma: Yüzme veya botla gezi sırasında alkol tüketimi veya yasadışı uyuşturucuların kullanımı, reaksiyon sürelerini yavaşlatabilir ve boğulma riskini artırabilir. Bu nedenle, yüzme veya su aktiviteleri sırasında alkol ve uyuşturuculardan kaçınılmalıdır.
- Ebeveynlerin çocuklarını denetlemeleri: Ebeveynler, çocuklarının yeterince denetlenmediği durumlarda, küvet, havuz, sığ su gibi alanlarda boğulma riskiyle karşılaşabilecekleri konusunda uyarılmalıdır. Bu tür alanlarda çocuklar yalnız bırakılmamalıdır.
Bu önlemler, boğulma vakalarının azaltılması ve suyla ilgili kazaların önlenmesi için kritik öneme sahiptir. Hem bireylerin hem de toplumun bu konuda bilinçlendirilmesi büyük önem taşır.
HASTA TAKİBİ
Semptomatik boğulma hastalarının tedavisinde, hastaneye yatış ve destekleyici bakım gereklidir. Ayrıca, organlara özgü komplikasyonların yönetimi de bu hastaların tedavisinde önemli bir yer tutar. İşte bu süreçte dikkate alınması gereken bazı temel tedavi yaklaşımları:
- Servikal omurga yaralanmalarının dışlanması: Eğer servikal omurga yaralanmalarından şüphe yoksa, hasta sırt üstü yatırılmalı ve yatağın başı 30 dereceye yükseltilmelidir. Bu pozisyon, özellikle beyin ve omurilik üzerindeki basıncı azaltmak için faydalıdır.
- Yüksek kafa içi basıncı: Boğulma sonrası hastalarda kafa içi basıncının yüksekliği gözlemlenebilir. Kafa içi basıncı izlemek ve bu durumu yönetmek, iyileşme sürecini etkileyebilir, ancak agresif tedbirlerin (örneğin, farmakolojik müdahaleler) ve kafa içi basınç izlemelerinin bu hastalarda genel sonuçları iyileştirdiğine dair yeterli kanıt yoktur ve nadiren uygulanmaktadır.
- Destekleyici bakım: Solunum desteği, sıvı elektrolit dengesi, sıcaklık kontrolü ve gerekli durumlarda sedasyon gibi destekleyici bakım unsurları hastanın durumuna göre ayarlanmalıdır. Oksijen tedavisi ve ventilasyon desteği, boğulma vakalarında genellikle önemlidir.
- Organa özgü komplikasyonların tedavisi: Örneğin, akciğerlerdeki hasar nedeniyle gelişebilecek pulmoner ödem veya diğer komplikasyonlar için spesifik tedavi gereklidir. Bu durumlar, hastanın klinik durumuna göre uygun tedavi protokollerine göre yönetilmelidir.
Boğulma sonrası hastalarda tedavi, stabilizasyon ve komplikasyonların önlenmesi amacıyla çok yönlü bir yaklaşım gerektirir. Yüksek kafa içi basıncı gibi durumlar nadiren agresif tedavi gerektirir, ancak hastanın durumunun dikkatle izlenmesi önemlidir.
PODCAST
KAYNAKLAR
- Schmidt AC, Sempsrott JR, Hawkins SC, Arastu AS, Cushing TA, Auerbach PS. Wilderness Medical Society Clinical Practice Guidelines for the Treatment and Prevention of Drowning: 2019 Update. Wilderness Environ Med . 2019 Dec;30(4S):S70-S86. doi: 10.1016/j.wem.2019.06.007.
- https://www.ahajournals.org/doi/10.1161/CIR.0000000000000916
- https://www.cprguidelines.eu/assets/guidelines/European-Resuscitation-Council-Guidelines-2021-Ca.pdf
- https://www.uptodate.com/contents/drowning-submersion-injuries/print
- https://www.jmo.org.tr/resimler/ekler/012de038b9894dc_ek.pdf
- https://www.jmo.org.tr/resimler/ekler/012de038b9894dc_ek.pdf
- https://acilci.net/bogulmanin-tedavisi-ve-onlenmesi-kilavuzu-wilderness-medical-society-2019-guncellemesi/
- https://dergipark.org.tr/tr/download/article-file/39366
- https://dergipark.org.tr/tr/download/article-file/183651
- https://www.ncbi.nlm.nih.gov/books/NBK430833/
- https://seyler.eksisozluk.com/su-alti-avciligi-ve-serbest-dalis-yapanlarin-korkularindan-biri-sig-su-bayilmasi
- https://www.acilcalisanlari.com/suda-bogulma-erc-2015-akil-karti.htm